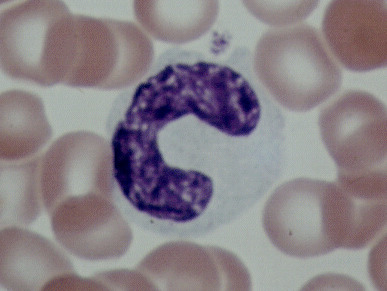
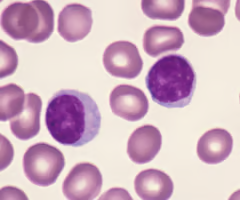
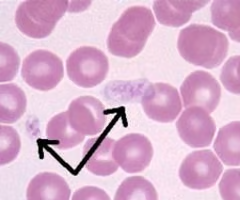

1/43
Looks like no tags are added yet.
Name | Mastery | Learn | Test | Matching | Spaced | Call with Kai |
|---|
No analytics yet
Send a link to your students to track their progress
monocyte
lymphocytes

neutrophil

eosinophil

basophil

what group of formed elements is this?
leukocytes
what group of formed elements is this?
thrombocytes

what group of formed elements is this?
erythrocytes

left auricle

right auricle

ligamentum arteriosum

superior vena cava

inferior vena cava

aorta

right brachiocephalic artery

left common carotid artery

left subclavian artery

pulmonary veins

{TYPE OF GROOVE}
atrioventricular sulci

{TYPE OF GROOVE}
anterior interventricular sulcus

{TYPE OF GROOVE}
posterior interventricular sulcus

pulmonary trunk

pulmonary artery

{OPENING IN CHAMBER}
opening of coronary sinus

{TYPE OF VESSEL}
coronary arteries

{TYPE OF BLOOD VESSEL}
coronary veins

apex of heart

right atrium

left atrium

right ventricle

left ventricle

interventricular septum

aortic semilunar valve

pulmonary semilunar valve

{TYPE OF VALVE}
right atrioventricular valve

{TYPE OF VALVE}
left atrioventricular valve

{GROOVES FOUND IN WALL}
trabeculae carneae

{ANCHORS OF HEART WALL}
papillary muscles

{TYPE OF FIBROUS CONNECTIVE TiSSUE}
chordae tendineae

{INDENTION IN THE CHAMBER}
fossa ovalis

epicardium

myocardium

endocardium

{TYPE OF BLOOD VESSEL}
coronary sinus